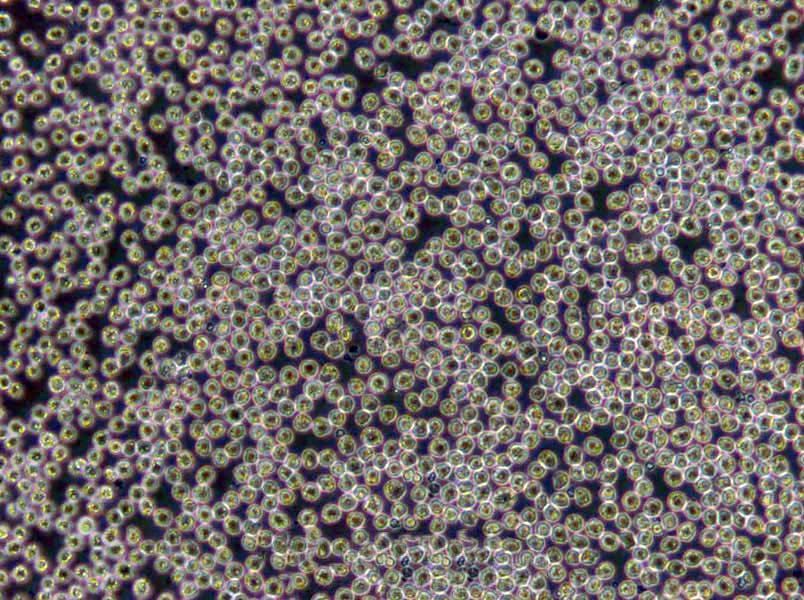
NCI-H2052 Cells(赠送Str鉴定报告)|人恶性胸膜间皮瘤细胞

"NCI-H2052 Cells(赠送Str鉴定报告)|人恶性胸膜间皮瘤细胞
细胞背景资料:详见相关文献介绍
细胞形态:上皮细胞样
接收细胞相关问题:如不能在收到细胞后及时操作细胞,T25及离心管发货的细胞将可以消毒后在37度过夜,血清发货的细胞在室温下静置1-2天(注意不要放冰箱),干冰发货的可以在确认干冰未完全升华时将细胞直接放回液氮或者-80度冰箱,若干冰完全升华,请即刻复苏细胞。T25瓶及离心管在培养箱平衡是为了让细胞尽快适应培养箱环境,同时使部分因运输导致脱落的细胞贴壁,此步骤非常必要。T25瓶如果在显微镜下可以看到部分不贴壁的细胞,可以收集上清后离心(1200rpm,5min)后,将沉淀用新的培养基重悬后接种至新的培养瓶或皿中。部分细胞在运输过程中,由于不断震荡及环境不适,可能导致细胞破碎死亡,从而使培养基中漂浮很多细胞碎片及颗粒状物质。这种情况下,平衡后,贴壁细胞用PBS洗两遍再加新的培养基培养或者传代至新瓶中培养即可;悬浮细胞可以离心(1000rpm,3min)收集细胞,并用PBS重悬后再离心一次,再用新的培养基重悬并接种细胞。
细胞生长:贴壁
NU-GC-3细胞类似产品::MGC803细胞、ACCM细胞、MC 116细胞
Emory University-2细胞类似产品::ME 180细胞、MDA-MB-157细胞、HIT clone T15细胞
Ocular Choroidal Melanoma-1细胞类似产品::XuanWei Lung Cancer-05细胞、A375-SM细胞、CHP 212细胞
He-La细胞类似产品::NCI-H1703细胞、J 82细胞、THP1细胞
PaTu8988s细胞类似产品::Hs863T细胞、HCEC-B4G12细胞、HPBALL细胞
NCI-H2052 Cells(赠送Str鉴定报告)|人恶性胸膜间皮瘤细胞
细胞物种来源:人源或鼠源等其它物种来源
[细胞产品包装]鲜活细胞:T25培养瓶(一瓶)或冻存细胞:1ml冻存管(两支)
在细胞培养过程中会出现这样或那样的问题,客户遇到的问题从细胞生长角度来说,针对细胞培养过程中生长不HAO、甚至死亡的原因,我们做以下分析并提出相对应的解决方法。一、培养细胞生长不HAO》可能原因:细胞本身的状态》1)细胞传代次数多,细胞老化;2)细胞的接种量:接种量过低,细胞生长缓慢;3)细胞传代时间过晚:细胞中毒,影响传代后的细胞生长;4)胰酶消化时间过长或过短:时间过长,细胞死亡;时间过短,细胞未完全分离而成团,细胞死亡;5)细胞的冻存与复苏:慢冻速融。污染:1)支原体污染;2)霉菌污染;培养基或血清:1)更换血清或培养基之前未进行验证;2)选择的培养基是否合适;3)培养基配制是否准确无误;培养环境:1)CO2供应是否正常;2)培养箱或摇床温度控制是否正确;解决方法:根据以上四个方面的可能原因,做出针对性的解决方案》1)注意细胞的本身状态:如传代次数、接种量等;2)避免产生污染(用正规、合法、可溯源的血清);3)要用合适的血清或培养基,ZuiHAO经过验证;4)注意实验室的环境;二、培养细胞死亡》可能原因:1)培养箱内无CO2;2)培养箱内温度波动太大;3)细胞冻存或复苏过程中损伤;4)培养液渗透压不正确;5)培养液中有毒代谢产物堆积;解决方法:1)检测培养箱内CO2;2)检查培养箱内温度;3)取新的保存细胞种;4)检测培养液渗透压;5)换入新鲜培养液。
细胞传代方法:1:3-1:6传代
A204细胞类似产品::HuT 102细胞、KY-270细胞、TK10细胞
NCI-H2342细胞类似产品::174xCEM.T2细胞、NCIH889细胞、hEEC细胞
GLC-82细胞类似产品::C2C12细胞、NCI-H292细胞、1E8-H细胞
SW-1088细胞类似产品::CEMO-1细胞、C17细胞、PL45细胞
PANC-04-03细胞类似产品::MPC-83细胞、ADR-RES细胞、H-II-E-C3细胞
细胞来源说明:来源于RCB、ATCC、KCLB、DSMZ、ECACC、INCell、ScienCell、ECACC、JCRB、Asterand、ICLC等知名细胞库
NCI-H2052 Cells(赠送Str鉴定报告)|人恶性胸膜间皮瘤细胞
细胞生长特性:贴壁生长
H-250细胞类似产品::H520细胞、Functional Liver Cell-7细胞、OUMS-27细胞
NCI-H250细胞类似产品::H-295细胞、H1341细胞、NCI-H226细胞
H-128细胞类似产品::NCI-H125细胞、UO-31细胞、H-9细胞
H1915细胞类似产品::MNNG/HOS细胞、AD293细胞、SCC 25细胞
RAW264.7细胞类似产品::SK MEL 5细胞、U-266细胞、Panc02-H0细胞
Hs940.T细胞类似产品::293 HEK细胞、UMNSAH-DF 1细胞、IGROV细胞
造成实验室细胞污染常见情况总结:细胞培养中Zui常见污染的是细菌、真菌和支原体污染。细胞一旦污染,大多数较难处理。那么,哪些情况我们不注意的话就会造成细胞污染呢?我们根据常见细胞培养实验分析总结下。【违规操作】1)为节省时间,有人已经用超净台四个多小时,不开紫外灭菌30min,酒精擦拭后直接开始试验;2)器材或者溶液很久没用,未检测是否污染而直接使用;离心管多次使用,枪头为了方便交叉使用;3)超净台不点酒精灯;点了酒精灯放在右上角,而你在左下角做试验;4)不带手套,徒手操作;5)细胞培养间配备枪式移液器、手术器械、离心机、冰箱等专用仪器设备以及专用的实验服和拖鞋,未定期消毒。专用物品被带出传代细胞使用。培养细胞过程中使用的所有实验用具,如移液管、一次性枪头、一次性塑料离心管、冻存管等未按要求灭菌使用(通常需121°CGAO压灭菌20分钟后37%烤干备用)。超净台和桌面,东西太多太乱:超净台不是储物箱,什么培养皿、各种规格的板子、枪头就不要堆在超净台!这样就会有许多紫外线顾不到的卫生死角。传代细胞其他的桌面,切忌东西堆积如山,不要将酒精棉球、标签纸、牛皮纸买来后全部堆在传代细胞!一不小心“飘”进你的细胞培养板里,细胞就会养的不HAO,啥时候死了都不知道!【培养箱太久没清洁】细胞污染了,并非直接扔了培养皿就不管了,首先你还得看看这个恒温培养箱里其他培养皿或孔板里的细胞是否污染,如果有而且HAO几个板子都有类似的污染块,那很可能是培养箱中的水或者空气污染了,得给培养箱做个大扫除,重新酒精消毒,照紫外;孵箱里的水,水没了要记得加,还得记得十天半个月的就用酒精擦擦托盘。【传代细胞人多口杂,难管理】在传代细胞这种卫生要求GAO,人多了,不确定因素多了,难以保证试验在无菌条件下操作。出入试验室,实验服当风衣穿,不扣纽扣,不戴,就容易造成细胞污染;超净台做实验时,喜欢说话聊着做试验,要是还不带口罩,里面就有很多细菌等着去攻击你的细胞呢!
细胞冻存复苏材料与方法步骤:常用的细胞冷冻贮存器为液氮贮存器,规格有35L和50L两种。使用时要注意以下几点:(1)一般两周需充液氮一次,至少一个月充氮一次。液氮温度达-196℃,使用时注意勿让液氮溅到皮肤上,以免引起冻伤。(2)液氮容器为双层结构,中间为真空层,瓶口有双层焊接处,应防止焊接部裂开。(3)在装入液氮时,要注意缓慢小心,并用厚纸卷筒或制漏斗作引导,使液氮直达瓶底,如有专用液氮灌注装置则更HAO。若为初次使用,加液氮时更要缓慢,以免温度骤降而使容器损坏。细胞冻存时常备的材料有:0.25%胰蛋白酶,含10%~20%的血清培养液,DMSO(分析纯)或无色新鲜甘油(121°C蒸气GAO压消毒),2mL安瓿(或专用细胞冻存管)、吸管、离心管、喷灯、纱布袋(或冻存管架)等。主要操作步骤为:(1)选择处于对数生长期的细胞,在冻存前一天ZuiHAO换液。将多个培养瓶中的细胞培养 液去掉,用0.25%胰蛋白酶消化。适时去掉胰蛋白酶,加入少量新培养液。用吸管吸取培养液反复吹打瓶壁上的细胞,使其成为均匀分散的细胞悬液。悬浮生产细胞则不要消化处理。然后将细胞收集于离心管中离心(1000r/min,10分钟)。(2)去上清液,加入含20%小牛血清的完全培养基,于4℃预冷15分钟后,逐滴加入已无菌的DMSO或甘油,用吸管轻轻吹打使细胞均匀,细胞浓度为3×106~1×107/mL之间。(3)将上述细胞分装于安瓿或专用冷冻塑料管中,安瓿装1~1.5mL在火焰喷灯上封口,封口处要完全封闭,圆滑无勾。冷冻管要将盖子盖紧,并标记HAO细胞名称和冻存日期,同时作HAO登记(日期、细胞种类及代次、冻存支数)。(4)将装HAO细胞的安瓿或冻存管装入沙布袋内;置于液氮容器颈口处存放过夜,次日转入液氮中。采用控制降温速度的方法也可采用下列步骤:先将安瓿置入4℃冰箱中2~3小时,再移至冰箱冷冻室内3~4小时,再吊入液氮容器颈气态部分存放2小时,Zui后沉入液氮中。细胞冻存在液氮中可以长期保存,但为妥善起见,冻存半年后,ZuiHAO取出一只安瓿细胞复苏培养,观察生长情况,然后再继续冻存。
MT-2J细胞类似产品::SKNAS细胞、FUOV1细胞、293/EBNA细胞
SCC-7细胞类似产品::NCIH2052细胞、COLO 320 DM细胞、SNG-M细胞
UCLA-SO-14细胞类似产品::NCI-H650细胞、HDSMC细胞、H-711细胞
HCE细胞类似产品::HEC-1-A细胞、SMA560细胞、LUDLU-1细胞
Hepa-RG细胞类似产品::SF 763细胞、DHL4细胞、NCIH1373细胞
P560细胞类似产品::HuT-78细胞、H889细胞、OVCAR-10细胞
WILL2细胞类似产品::H-128细胞、CORL279细胞、OVCAR-4细胞
M109细胞类似产品::JAR细胞、RGC5细胞、Hs895.T细胞
SGC996细胞类似产品::HEI-193细胞、HDF-a细胞、SNU-407细胞
HCC0070细胞类似产品::NCIH1395细胞、TO 175.T细胞、DHL-16细胞
Panc 5.04细胞类似产品::WBF344细胞、CA-OV-3细胞、MESSA Dx5细胞
Madin Darby Bovine Kidney细胞类似产品::LU65细胞、JB6 [Mouse]细胞、H1623细胞
58F细胞类似产品::BNL CL2细胞、H1395细胞、NCI-H2135细胞
OVCAR 433细胞类似产品::COLO394细胞、SMMC7721细胞、RPMI 8226细胞
SKRC-20细胞类似产品::NCI-H2342细胞、JOSK-M细胞、SUM 52细胞
ES2细胞类似产品::OCI AML5细胞、ChaGo-K1细胞、32D/cl3细胞
ES2细胞类似产品::OCI AML5细胞、ChaGo-K1细胞、32D/cl3细胞
SAS细胞类似产品::GA-10-Clone-4细胞、NPA细胞、H-650细胞
293细胞类似产品::NPA87细胞、HT-144细胞、A875细胞
H2227细胞类似产品::ARPE19细胞、TW01细胞、COLO 741细胞
BC-3H-1细胞类似产品::H766T细胞、BALB/3T3 (clone A31)细胞、MCA 205细胞
H-7721细胞类似产品::TSU-Pr1细胞、TGBC-11-TKB细胞、HEp-2细胞
Hs-578Bst细胞类似产品::MN 60细胞、P3-Jiyoye细胞、UMR-106细胞
GM07404细胞类似产品::639-V细胞、Pa017C细胞、OCI/AML-5细胞
Bovine Turbinate细胞类似产品::MARC-145细胞、TCC-PAN2细胞、RPMI-1846细胞
BeWo细胞类似产品::SU-DHL-5细胞、TE-3A细胞、UM-UC-3细胞
138 MG细胞类似产品::HCC-9724细胞、A-204细胞、C2BBe1细胞
22Rv-1细胞类似产品::SGC7901细胞、HCC-70细胞、Monomac-1细胞
G361-mel细胞类似产品::KBM-5细胞、TK-1细胞、REC 1细胞
EBNA-293细胞类似产品::SKNBE(1)细胞、QBC(939)细胞、GP5d细胞
MG-63细胞类似产品::TEV-1细胞、NRK-52E细胞、FK81细胞
HEK293E细胞类似产品::RPMI-7951细胞、H920细胞、Tn-5B1-4细胞
SNU-C1细胞类似产品::NGP细胞、GLAG-66细胞、Ly7细胞
NIH-3T3-L1细胞类似产品::Sup T-1细胞、B4G12细胞、RM1细胞
L cells细胞类似产品::HMC3细胞、M619细胞、MKN 28细胞
PTK 2细胞类似产品::COLO 699细胞、NS1-Ag4/1细胞、hCMEC/D3细胞
HSCT6细胞类似产品::LSECs细胞、BI-Mel细胞、SVGp12细胞
SHI-1细胞类似产品::T24(ECV304)细胞、C32r细胞、A 172细胞
PL 5细胞类似产品::U 266细胞、HT144-mel细胞、D10.G4.1细胞
A 2780 CP细胞类似产品::SW-620细胞、SKNBE-1细胞、NCI-H1838细胞
HT 1197.T细胞类似产品::RBSMC细胞、RMS 13细胞、KNS-42细胞
NCI-H2052 Cells(赠送Str鉴定报告)|人恶性胸膜间皮瘤细胞
LLC-MK2细胞类似产品::Primary Liver Carcinoma/Poliomyelitis Research Foundation/5细胞、PC3细胞、L-M (TK-)细胞
T98-G细胞类似产品::H-28细胞、D341 Med细胞、OV1/P细胞
TALL1细胞类似产品::VERO76细胞、293-H细胞、SHZ-88细胞
HeLa 229细胞类似产品::NTERA-2cl.D1细胞、LS 180细胞、FRTL5细胞
KP-4细胞类似产品::ES-2细胞、IR983F细胞、P-19细胞
KP-4细胞类似产品::ES-2细胞、IR983F细胞、P-19细胞
1.1B4细胞类似产品::LN-18细胞、GM637A细胞、Human Kidney-2细胞
CAL-78细胞类似产品::NCI-H1435细胞、COLO 680N细胞、Ontario Cancer Institute-Acute Myeloid Leukemia-5细胞
Hs343T细胞类似产品::Colon 26细胞、HPDLF细胞、FAO-1细胞
SNT-8细胞类似产品::Vero E-6细胞、HPAEC细胞、HET-1A细胞
SL1细胞类似产品::Cates-1B细胞、NCI-H2347细胞、TFK1细胞
KCL-22细胞类似产品::Central Adrenergic TH-expressing a细胞、MKN28细胞、SaOS细胞
SK-MEL2细胞类似产品::COLO824细胞、NCIH2286细胞、NBL-2细胞
HEK-293 c18细胞类似产品::brain-derived Endothelial cells.3细胞、Caki2细胞、GES-1细胞
HEK-293 c18细胞类似产品::brain-derived Endothelial cells.3细胞、Caki2细胞、GES-1细胞
MDA330细胞类似产品::Pt K2细胞、PG [Human lung carcinoma]细胞、ROS-17/2.8细胞
HSC3细胞类似产品::Panc3_27细胞、NCI-H498细胞、HuTu-80细胞
D 407细胞类似产品::HCT 15细胞、293 HEK细胞、ECC12细胞
L-M (TK-)细胞类似产品::Sp2/0细胞、SKGT2细胞、SKG IIIa细胞
PAMC82细胞类似产品::mousepodocyte细胞、RIN14B细胞、Homo sapiens No. 578, tumor cells细胞
NCI-157细胞类似产品::KP-N-RT细胞、NCIH378细胞、HCC0038细胞
HTori-3.1细胞类似产品::BEL-7405细胞、TEC细胞、P3HR-1细胞
GM02219D细胞类似产品::RMa-bm细胞、WSU-DLCL2细胞、HFT8810细胞
MOLM13细胞类似产品::CAL 85-1细胞、HCC-1954BL细胞、Hep-3B细胞
H-647细胞类似产品::Kit225/K6细胞、P3X63 AG 8.653细胞、NRK49F细胞
IMR 90细胞类似产品::SNU-398细胞、SCLC-21H细胞、Sp2/mIL-6细胞
Panc2.03细胞类似产品::AMJ2-C8细胞、U266BL细胞、C 6细胞
TSU-Pr1细胞类似产品::H1568细胞、COLO-829细胞、R.K.13细胞
BA/F3细胞类似产品::DSL-6A-C1细胞、HEP-3B2细胞、MDA-MB468细胞
RINm5F细胞类似产品::AMO1细胞、U138MG细胞、SKHEP-1细胞
UM-UC3细胞类似产品::HEC1A细胞、H1299细胞、HD-LM-2细胞
293GP细胞类似产品::BT.549细胞、H-23细胞、R3/1细胞
2B4细胞类似产品::MOPC细胞、PK 15细胞、KY180细胞
hs 68细胞类似产品::MSB1细胞、MOLP-2细胞、RBL2H3细胞
TK-10细胞类似产品::Panc 03.27细胞、FLC-7细胞、Hep2细胞
MPC-83细胞类似产品::PL9细胞、MC 116细胞、H1355细胞
OCM1A细胞类似产品::686LN-M4e细胞、C-Lu-65细胞、HUT 226细胞
Stanford University-Diffuse Histiocytic Lymphoma-8细胞类似产品::AGS细胞、P388.D1细胞、P3X63 AG8-653细胞
MDA-MB-436细胞类似产品::CCRF/CEM/0细胞、MRASMC细胞、SCC090细胞
159PT细胞类似产品::NCI-H2122细胞、SuDHL 8细胞、CCD-1112sk细胞
S37细胞类似产品::HBE135-E6E7细胞、Jurkat, Clone E6-1细胞、NCIH716细胞
HN4细胞类似产品::LA4细胞、MDA361细胞、H-1618细胞
SNU-869细胞类似产品::P 3 HR 1细胞、Uhth-74细胞、T-98细胞
R1610细胞类似产品::H510细胞、Murine Thymic Epithelial Cell line 1细胞、HUT 28细胞
KYSE270细胞类似产品::2780CP细胞、P3JHR1细胞、BALB/3T3细胞
CCD841CoN细胞类似产品::Molm 14细胞、Hep2细胞、Hs742T细胞
KP-N-RT细胞类似产品::NCIH1563细胞、Ca-Ski细胞、HG2855细胞
TE5细胞类似产品::MN-9D细胞、NCI-H2066细胞、TE-5细胞
H1963细胞类似产品::SK Col 1细胞、GA-10 clone 4细胞、MCF-7/ADR细胞
3T3-A31细胞类似产品::RBE细胞、Sun Yat-sen university Ophtalmic center-Retinoblastoma 50细胞、SupB15WT细胞
JROECL 21细胞类似产品::KATOIII细胞、MD Anderson-Metastatic Breast-231细胞、MeT5A细胞
BOWES细胞类似产品::T 24细胞、MDA 435细胞、3T3-A31细胞
OVCA433_Bast细胞类似产品::AE 1201细胞、Bat lung细胞、T1-73细胞
Cloudman S91 melanoma细胞类似产品::COLO 206细胞、CAL39细胞、NCI-522细胞
HT55细胞类似产品::SUM 159PT细胞、UM-UC-14细胞、ML-2细胞
SK-Hep1细胞类似产品::Hepatoma 22细胞、YH细胞、Mink Lung细胞
WIL2-S细胞类似产品::COLO 824细胞、TH1细胞、HRPEpiC细胞
CX-1细胞类似产品::MIA-Pa-Ca-2细胞、BV-2细胞、GM03320细胞
AC29细胞类似产品::HEC-1-B细胞、H8细胞、GM3190细胞
HCC0038细胞类似产品::U-373MG细胞、Hs688(A)T细胞、J-774细胞
B-104细胞类似产品::COLO-320DM细胞、SaOS细胞、RMS 13细胞
NALM-6细胞类似产品::RCCJF细胞、NIH:OVCAR3细胞、MCF.7细胞
LS-513细胞类似产品::NCIH1792细胞、OCIAML4细胞、brain-derived Endothelial cells.3细胞
COLO_320DM细胞类似产品::HANK-1细胞、SUDHL-8细胞、H22细胞
MKN7细胞类似产品::Panc 1细胞、HS-445细胞、WM266mel细胞
BE2C细胞类似产品::H.Ep.-2细胞、DLD1细胞、LA4细胞
MV-4:11细胞类似产品::SUM-159-PT细胞、FHs74 Int细胞、H-1755细胞
SF539细胞类似产品::K562细胞、SJ-Rh 30细胞、3T3NIH细胞
TC7细胞类似产品::KMBC细胞、LC2/Ad细胞、A-72细胞
A2780细胞类似产品::RMG1细胞、Sf21细胞、CCD 841 CoTr细胞
PC10细胞类似产品::MIMVEC细胞、BNCL2细胞、NCI-H2106细胞
MIMVEC细胞类似产品::A2780细胞、CCLP1细胞、SW-780细胞
CTX TNA2细胞类似产品::JB-6 Cl 30细胞、USMC细胞、C-32细胞
NPA-87细胞类似产品::RC92A细胞、H-4细胞、SUPT-1细胞
Astrocyte type I clone细胞类似产品::NCI-SNU-1细胞、H2.35细胞、SHI1细胞
MRC-V细胞类似产品::Human Pancreatic Duct Epithelial细胞、HSC 3细胞、HO8910细胞
SNUC2A细胞类似产品::A 549细胞、Panc_02_03细胞、Michigan Cancer Foundation-12A细胞
Hs 863.T细胞类似产品::CHO-Lec1细胞、A431细胞、WEHI-231细胞
VK2 (E6/E7)细胞类似产品::COLO-320细胞、GM0637细胞、CNE1-LUC细胞
KPNRTBM1细胞类似产品::32D clone3细胞、H 9细胞、CP-70细胞
SuDHL 5细胞类似产品::Hs 578.Bst细胞、LS-411细胞、ChaGo K-1细胞
COLO-741细胞类似产品::HPAF2细胞、Swiss/3T3细胞、MDA-435细胞
MCF-10 Attached细胞类似产品::NCIH929细胞、E6-1细胞、RL952细胞
SKNEP1细胞类似产品::PG-LH7细胞、BV173细胞、HT3细胞
MIMVEC细胞类似产品::A2780细胞、CCLP1细胞、SW-780细胞
C-6细胞类似产品::MRC9细胞、JIMT细胞、GM-637细胞
WM2664细胞类似产品::A-172 MG细胞、P3J HR1-K细胞、KYSE 50细胞
H-774细胞类似产品::GM00637细胞、SKNBE细胞、GB-1细胞
NKM1细胞类似产品::ECC 10细胞、RD-2细胞、766T细胞
EFO 27细胞类似产品::TU 686细胞、Kit-225细胞、JB6 [Mouse]细胞
GA-10细胞类似产品::NIH3T3-L1细胞、HIEC-6细胞、K1细胞
Duke University 4475细胞类似产品::SUM-190PT细胞、EM3细胞、CMT64细胞
Hep G2-Luc细胞类似产品::SUDHL-5细胞、A673细胞、Ls-174-T细胞
HEK293-H细胞类似产品::SKNMC细胞、OCI AML4细胞、U87MG细胞
GM637A细胞类似产品::HO-8910 PM细胞、686LN-M4e细胞、Hs 746.T细胞
NCI-H2085细胞类似产品::L-6细胞、H-7721细胞、HT55细胞
NCI-H1648细胞类似产品::CT26-clone 25细胞、UPCI:SCC154细胞、MSTO-211H细胞
CMT.64细胞类似产品::Mv.1.Lu细胞、NCI-H2135细胞、Mel-RM细胞
NCI-HUT-520细胞类似产品::P3J HR-1细胞、RS(4;11)细胞、MF2059细胞
MKN1细胞类似产品::MDCK2细胞、KLN-205细胞、Ly3细胞
Murine Thymic Epithelial Cell line 1细胞类似产品::T-84细胞、Lilly Laboratories Cell-Porcine Kidney 1细胞、PA I细胞
CL-11细胞类似产品::University of Michigan-Urothelial Carcinoma-1细胞、MGH-U3 (RN)细胞、RC13细胞
NCI-446细胞类似产品::RM1细胞、H1522细胞、Intestinal Porcine Epithelial Cell line-1细胞
MPP89细胞类似产品::HNEpC细胞、WM-2664细胞、Jeko1细胞
Karpas 299细胞类似产品::HNE-1细胞、U-118MG细胞、WERIRb1细胞
SNU-C1细胞类似产品::NGP细胞、C1R细胞、SBC-3细胞
CAKI 2细胞类似产品::RMS13细胞、A-20细胞、CL1-0细胞
CWR22-Rv1细胞类似产品::P3-X63-Ag8-6-5-3细胞、Hs822T细胞、Panc203细胞
MDA231-LM2-4175细胞类似产品::CSQT-2细胞、Leukemia L1210细胞、HCT-FET细胞
HCC-70细胞类似产品::Swiss/3T3细胞、HBL100细胞、C8D1A细胞
Scott细胞类似产品::GOS3细胞、SCC 4细胞、SW1116细胞
BE2-C细胞类似产品::HCT/FU细胞、U-2-OS细胞、NCI-841细胞
LOUNH91细胞类似产品::CCD-112 CoN细胞、HSC-T6细胞、Vx-2细胞
SKRC-42细胞类似产品::H-1618细胞、Ra No. 1细胞、NK-92MI细胞
H2452细胞类似产品::BrCL12细胞、PTK2细胞、EB2细胞
SK-MEL-28细胞类似产品::HSF细胞、AQ-Mel细胞、4-1st细胞
IM-95细胞类似产品::A-204细胞、AMJ2-C8细胞、JB6 Cl 30-7b细胞
H676B细胞类似产品::CEM T4细胞、AN3细胞、ROS1728细胞
YH细胞类似产品::NL-20细胞、Virginia Mason Research Center-Lung Cancer D细胞、NCIH596细胞
NCI-H2052 Cells(赠送Str鉴定报告)|人恶性胸膜间皮瘤细胞
SCL-I细胞类似产品::WM-266-4细胞、UCLA-SO-M20细胞、NCI-H647细胞
Rat podocyte细胞类似产品::WM 239-A细胞、HCC2185细胞、CHL-1细胞
C-6细胞类似产品::MRC9细胞、JIMT细胞、GM-637细胞
SK_N_BE2C细胞类似产品::MSTO-211 H细胞、NCI-H865细胞、NCIH2126细胞
LS411N细胞类似产品::H-510细胞、GM2219C细胞、MC-CAR细胞
SKHEP-1细胞类似产品::SNT-8细胞、NCI-H1436细胞、Human Microvascular Endothelial Cell line-1细胞
OEC19细胞类似产品::TE671细胞、PE/CA-PJ34细胞、Mia PACA 2细胞
TE 85 ClF-5细胞类似产品::IGROV细胞、Neuro 2a细胞、NCI-SNU-886细胞
A-549细胞类似产品::MDAMB468细胞、HCC1937细胞、P30-OHK细胞
NOR10细胞类似产品::NCI-SNU-387细胞、SL-29细胞、UM-UC14细胞
UMNSAH/DF-1细胞类似产品::NCM-460细胞、NCIH1666细胞、H-1993细胞
NCI-H1915细胞类似产品::NCIADRRES细胞、NCI-H2195细胞、SK-N-BE-2c细胞
IEC-18细胞类似产品::McA-RH7777细胞、CTV1细胞、Kit 225细胞
OV1/P细胞类似产品::CA46细胞、MDAMB435细胞、CCD18细胞
A-375细胞类似产品::H647ell细胞、A.704细胞、Hs683T细胞
CL34细胞类似产品::HuP-T4细胞、RCCJF细胞、OCI AML3细胞
Ca761细胞类似产品::NCIH2170细胞、ST细胞、PTK 1细胞
NCIH1048细胞类似产品::SW-1573细胞、OCIAML5细胞、MDCC-MSB1细胞
293 Ad5细胞类似产品::MO59J细胞、639V细胞、NCIADR.RES细胞
C-28/I2细胞类似产品::C-32细胞、L-5178-Y-R细胞、BNCL-2细胞
H-1648细胞类似产品::OVCAR-3细胞、MLMEC细胞、CPA47细胞
Colo-201细胞类似产品::NK-92 MI细胞、BEL 7404细胞、Ha Fe细胞
PBMC细胞类似产品::kms 11细胞、LLC-MK-2细胞、526-mel细胞
MC-CAR细胞类似产品::NSH细胞、SKLU1细胞、BE2M17细胞
KP 4细胞类似产品::Saos2细胞、D341Med细胞、CCD 19Lu细胞
COLO 320F细胞类似产品::G-402细胞、IAR-20细胞、Immortalized Human Hepatocytes细胞
MMQ细胞类似产品::Potorous tridactylus Kidney 2细胞、PANC0504细胞、EBTr (NBL-4)细胞
HCEC-12细胞类似产品::GM-637细胞、HSF2细胞、Normal Rat Kidney-49F细胞
CAL 12T细胞类似产品::HOS-TE85细胞、T8细胞、HaCaT细胞
PCI:SG231细胞类似产品::NCTC-1469细胞、Tb 1-Lu细胞、SW-1417细胞
UCLA-SO-14细胞类似产品::NCI-H650细胞、QSG-7701细胞、BE2_C细胞
C127细胞类似产品::HCC-70细胞、LTEP-sm细胞、QGY-7703细胞
"